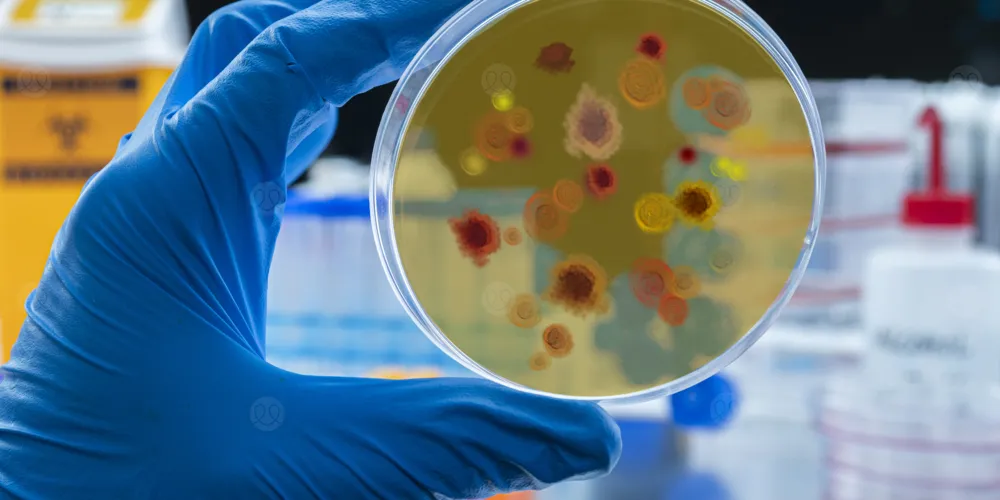

في خطوة علمية واعدة، توصّل فريق دولي من العلماء إلى أن أنواعاً معينة من البكتيريا التي تعيش داخل هذه الأورام قادرة على إنتاج جزيء قوي لا يهاجم الخلايا السرطانية فحسب، بل يعزز أيضاً فعالية العلاج الكيماوي بشكل كبير.
هذا الجزيء، الذي أطلق عليه اسم "2-MiCit" يفتح الباب أمام استراتيجيات علاجية جديدة ومبتكرة، مستوحاة من الميكروبات التي تسكن أجسامنا، وقد يؤدي إلى تطوير جيل جديد من الأدوية التي تجعل العلاجات الحالية أكثر فتكاً بالخلايا السرطانية.
بكتيريا تعيش داخل الأورام
لطالما عرف العلماء بوجود ميكروبات في الجلد والأمعاء، لكن الاكتشافات الحديثة أظهرت أن الأورام نفسها تستضيف مجتمعات بكتيرية فريدة. ومع التقدم في تقنيات التحليل الجزيئي، بدأ الباحثون بفهم الدور الحقيقي الذي تؤديه هذه الميكروبات في نمو الأورام، واستجابتها للعلاج.
وفي دراسة حديثة نُشرت في مجلة Cell Systems، قاد فريق من العلماء من مختبر العلوم الطبية (LMS) في لندن بالتعاون مع إمبريال كوليدج لندن، وجامعة كولونيا الألمانية هذا الإنجاز الذي قد يمثل نقطة تحول في فهم العلاقة بين الميكروبات والسرطان.
كيف يحارب الجزيء البكتيري الخلايا السرطانية؟
كشفت الدراسة أن جزيء 2-MiCit يعمل عبر شن هجوم مزدوج على الخلايا السرطانية:
- أولًا، يستهدف الميتوكوندريا، وهي مصنع الطاقة في الخلية، ويثبط إنزيمًا أساسيًا فيها، مما يُضعف قدرتها على البقاء.
- ثانيًا، يؤدي هذا التثبيط إلى تلف الحمض النووي، وتفعيل مسارات خلوية توقف نمو الورم.
والأهم من ذلك، أن هذا الهجوم يُضعف الخلية السرطانية، ويجعلها أكثر حساسية وهشاشة أمام العلاج الكيماوي. فعند استخدامه مع دواء السرطان الشائع "5-فلورويوراسيل"، أظهر جزيء 2-MiCit تعزيزًا قوياً، حيث كانت فعالية هذا المزيج في قتل الخلايا السرطانية أعلى بكثير من فعالية أي منهما بمفرده.
جيل جديد من الأدوية السرطانية
يشرح البروفيسور فيليبي كابريرو، قائد فريق البحث، أهمية الاكتشاف قائلاً: "كنا نعلم أن البكتيريا مرتبطة بالأورام، والآن بدأنا نفهم طبيعة المحادثة الكيميائية التي تجريها مع الخلايا السرطانية. وجدنا أن إحدى هذه المواد الكيميائية البكتيرية يمكن أن تعمل كشريك قوي للعلاج الكيماوي، مما يعطل عملية التمثيل الغذائي للخلايا السرطانية، ويجعلها أكثر هشاشة للدواء".
ولم يتوقف الفريق عند هذا الحد. بالتعاون مع الكيميائيين الطبيين، نجح الفريق في تعديل الجزيء طبيعي المنشأ للحصول على نسخة اصطناعية أكثر فعالية، وأظهرت التجارب أن النسخة المطوَّرة كانت أكثر قدرة على قتل الخلايا السرطانية، مما يفتح الباب أمام جيل جديد من الأدوية الميكروبية المستوحاة من الطبيعة.
من جانبه، يقول الدكتور دانيال مارتينيز-مارتينيز، الباحث الرئيسي في الدراسة: "الميكروبات جزء أساسي منا. إن قدرة جزيء واحد على إحداث مثل هذا التأثير العميق على تطور السرطان أمر رائع حقاً، ودليل آخر على مدى تعقيد علم الأحياء".
يمكنكم الآن الحصول على استشارة طبية عن بُعد من المنزل، عن طريق موقع الطبي.
 تسجيل دخول
تسجيل دخول